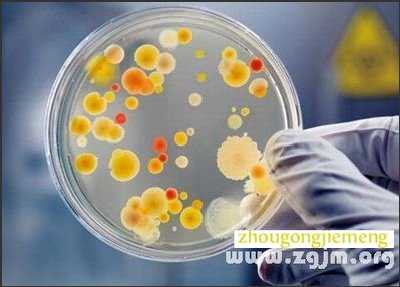
μණ

梦见脏东西,是好兆头,身体会健康。
梦见你的衣服忽然沾上了脏脏的东西,这是吉利之梦,表示你的上司或是老板会施恩于你,有可能是你长期得不到的东西他会送给你,或是很难解决的问是他也帮你解决了。
梦见好多脏水,有口舌之争。
梦见喝脏水,如果是睡觉前没喝水太渴了,到了梦里,看到脏水就喝,为无意义之梦;如果不是则身体会有病。
梦见用脏水洗澡,亲属或朋友将会长逝。
梦见脏水喷泉,是不幸的兆头。
梦见脏东西的案例分析
梦境描述:梦见自己去很偏远的公厕去上厕所,一脚踩到屎上,太恶心了,上衣上不知怎么蹭到很多土恶心死了。
梦境解析:恭喜你,这是好兆头,梦见脏东西,尤其是屎,代表你财运很旺哦!